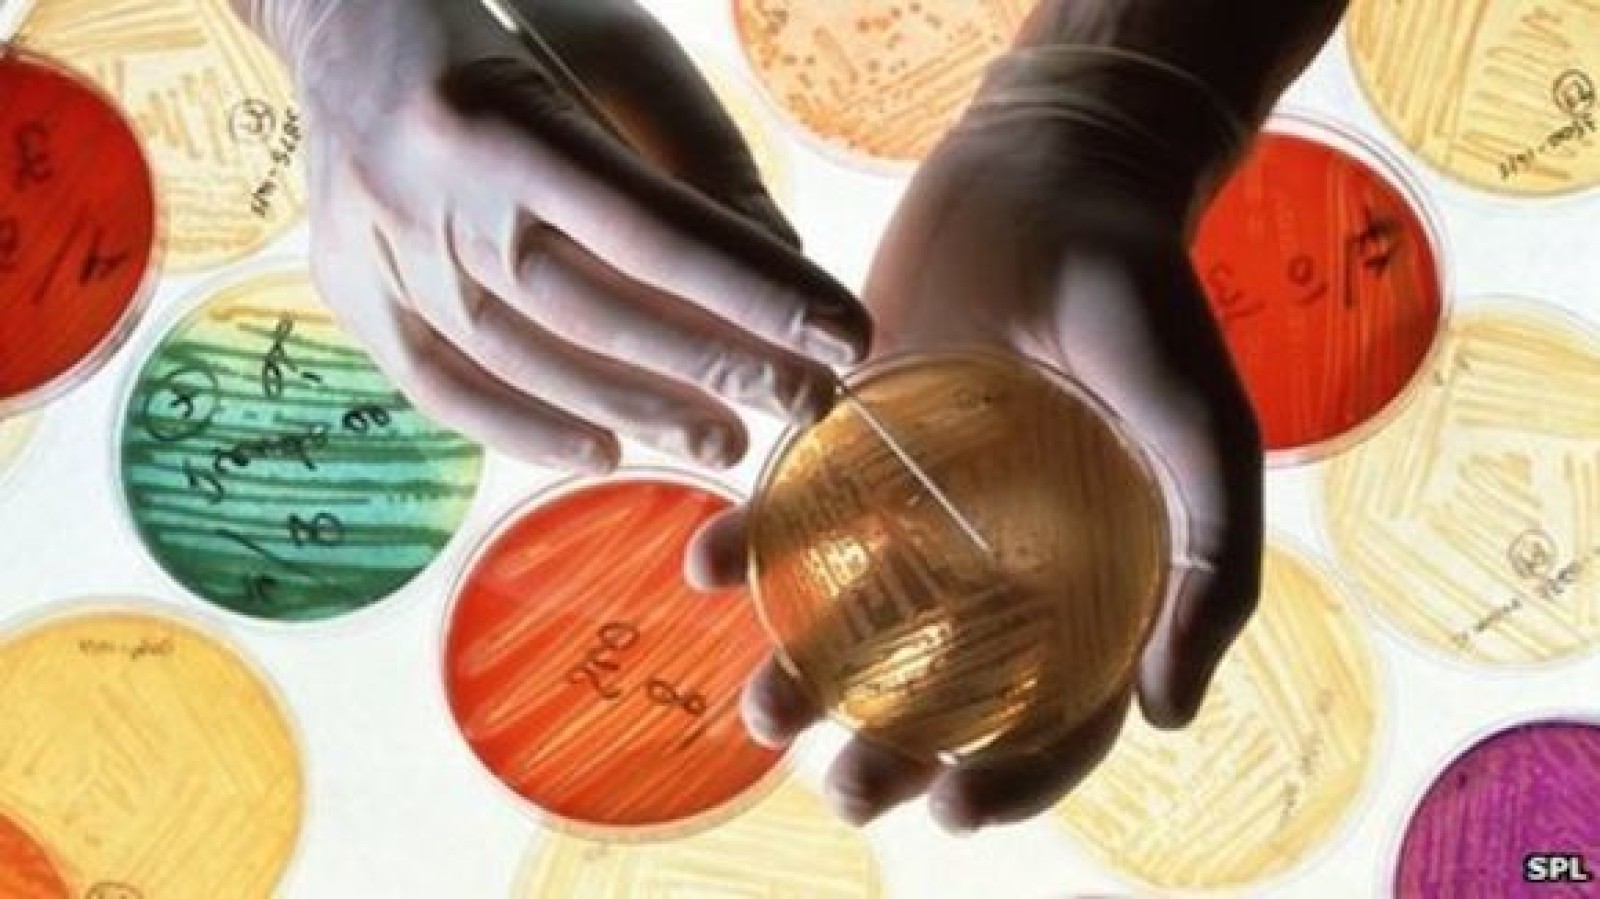

Online soon: new methodology for Antimicrobial Resistance Benchmark
During 2017, the Foundation has consulted with stakeholders and experts working in AMR to build consensus on the pharmaceutical industry’s role in the AMR space. The Foundation has examined companies’ responsibilities in a wide range of areas, including appropriate access, stewardship, R&D and production. The emerging consensus has been translated by the Foundation’s research team into the methodology for the first Antimicrobial Resistance Benchmark.
The Benchmark will be the first independently developed tool to focus specifically on the pharmaceutical industry’s response to AMR. It will drive change by identifying and sharing effective actions companies can take, and by uncovering how progress can be achieved. The Benchmark will complement existing initiatives monitoring progress on AMR. For example, the Pew Charitable Trusts track antibiotics now being developed; the US Center for Disease Dynamics, Economics & Policy publishes data on antibiotic use and antimicrobial resistance in a group of countries; the Farm Animal Investment Risk & Return initiative measures farming practices related to antibiotics use.
The Methodology for the Antimicrobial Resistance Benchmark will be published on the Foundation’s website in the coming weeks. The Benchmark is funded by the UK Department for International Development and the Dutch Ministry of Health, Welfare and Sport.
Ten years tracking pharma companies
To develop the Antimicrobial Resistance Benchmark, the Access to Medicine Foundation is building on its ten years of experience in tracking pharmaceutical company behaviour when it comes to making medicine accessible by the poor. The Foundation’s first industry benchmark, the Access to Medicine Index, is now in its fifth version. In March 2017, the Foundation published the first Access to Vaccines Index. These Indices both compare and track companies’ performances against stakeholder expectations.
About the Access to Medicine Foundation
The Access to Medicine Foundation is an independent, nonprofit organisation based in the Netherlands. It aims to advance access to medicine in low- and middle-income countries by stimulating and guiding the pharmaceutical industry to play a greater role in improving access to medicine. The Foundation is funded by the Bill & Melinda Gates Foundation, the Dutch Ministry of Foreign Affairs and the UK Department for International Development. For ten years, the Foundation has been building consensus on the role for the pharmaceutical industry in improving access to medicine and vaccines. It published its first benchmark of industry activity in this area in 2008, in the first Access to Medicine Index. The fifth Access to Medicine Index was published in November 2016. In 2017, the Foundation will publish the first Access to Vaccines Index, funded by the Dutch National Postcode Lottery, and the first AntiMicrobial Benchmark, funded by the UK and Dutch governments.